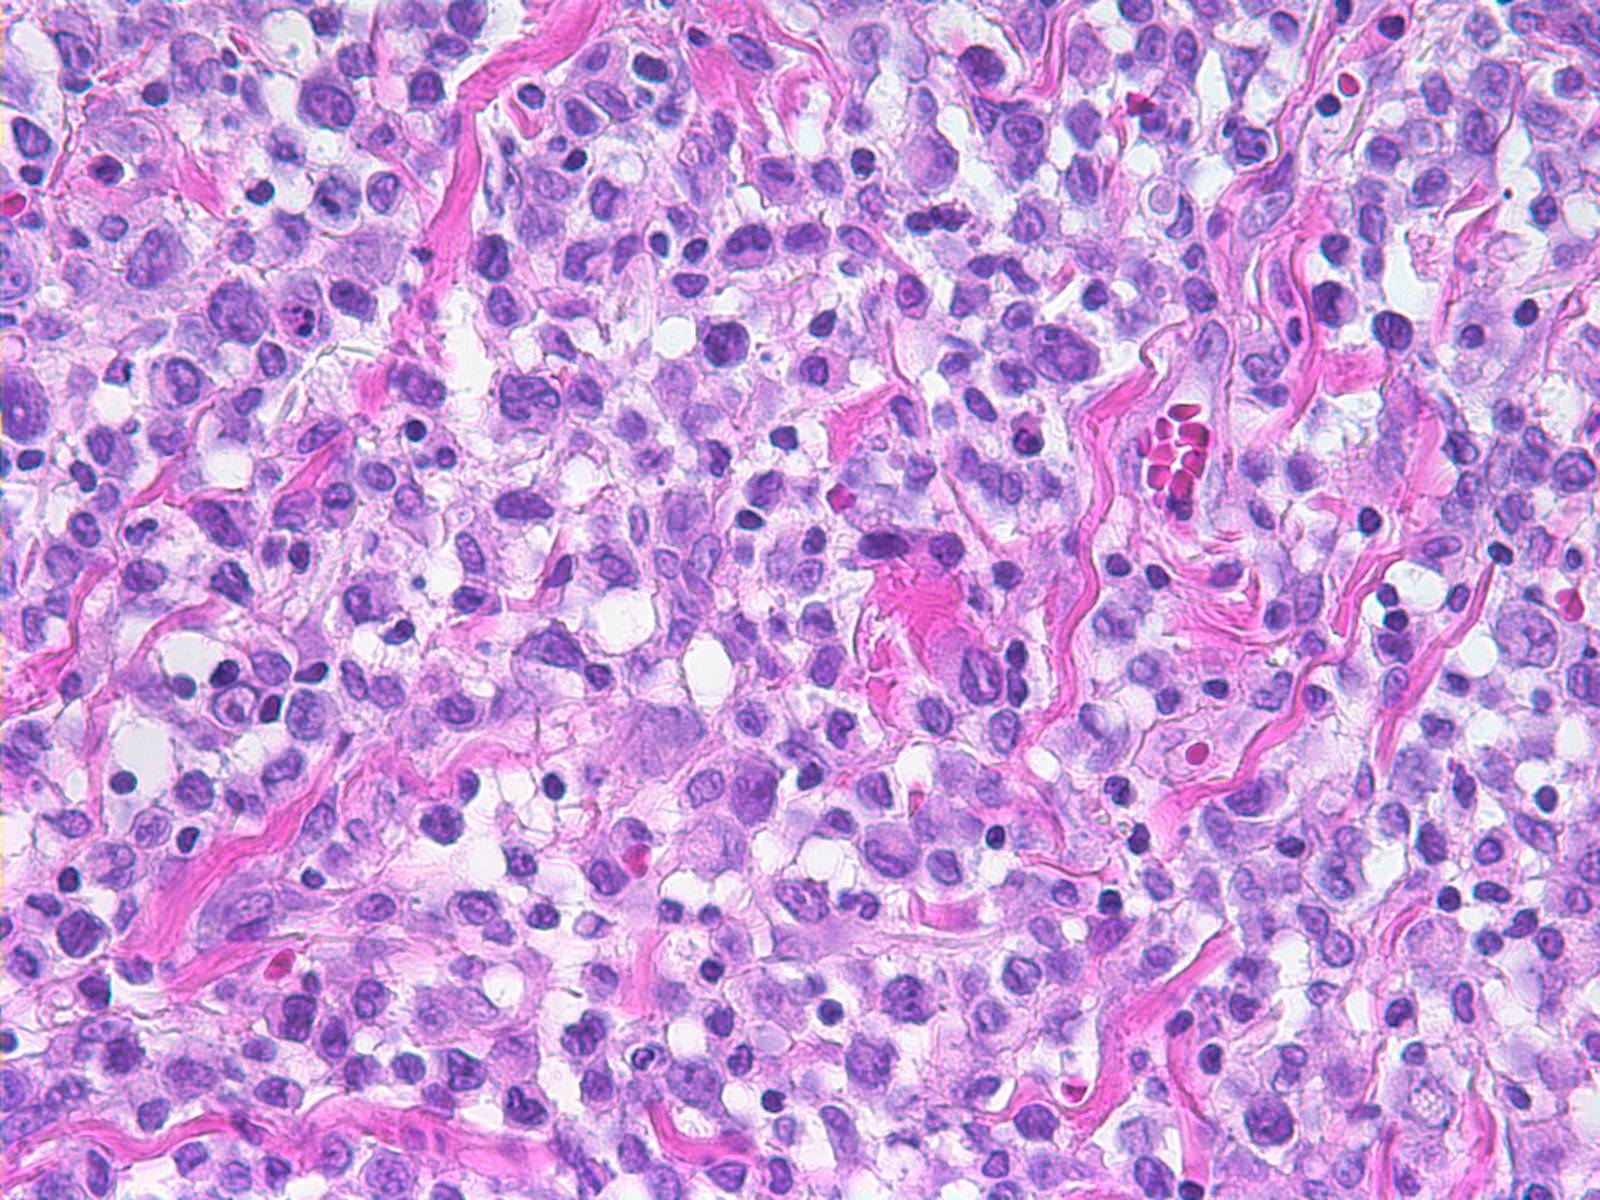
ALK Anaplastic Large cell Lymphoma

Director, Bruce Woda, MD
About Us
Faculty
Hours of Operation
Specimen Requirements and Transportation
Requisition
Contact Information
The Hematopathology service at UMass Memorial Medical Center provides skilled interpretation of specimens from the bone marrow, lymph node, spleen and extranodal sites. We have a special interest in histiocytic proliferative disorders, cutaneous lymphoproliferative disease and flow cytometric diagnosis.
The Hematopathology service is staffed by three expert hematopathologists and serves the UMass Memorial Medical Center and hospitals and hematology practices throughout Central Massachusetts.
Our mission is to provide outstanding clinical service, advance knowledge in the field of hematopathology and to provide training for residents and fellows.
Dr. Bruce Woda
 Monday through Friday: 8:00 am – 5:00 pm. Emergency specimens can be processed on Saturday or Sunday. The laboratory must be notified by 12 noon and the specimens must arrive by 1 pm. For Saturday emergency specimens, please page the clinical pathology residents at 7899. The hematopathologist on call can be reached through the UMass Memorial Medical Center operator at 508-334-1000.
Monday through Friday: 8:00 am – 5:00 pm. Emergency specimens can be processed on Saturday or Sunday. The laboratory must be notified by 12 noon and the specimens must arrive by 1 pm. For Saturday emergency specimens, please page the clinical pathology residents at 7899. The hematopathologist on call can be reached through the UMass Memorial Medical Center operator at 508-334-1000.
Specimen Requirements and Transportation
Bone marrow aspirate: Minimum of 2 ml in a heparinized (green top) tube, store at room temperature.
Peripheral Blood: One EDTA (preferred; purple top) tube or heparinized (green top) tube with at least 5 ml of blood, store at room temperature.
Lymph node biopsy or other type of surgical specimen: minimally 5x5x5 mm portion of fresh lymph node (or other type of tissue) in tissue culture medium, store at 2-8°C (wet ice). Normal saline may be used if culture medium is unavailable and transport time is kept to a minimum.
Body fluids: Require a minimum of approximately 100,000 cells (e.g. 100 cells/ ul x 1 ml; 10 cells /ul x 10 ml) and store at 2-8°C (wet ice).
Fine needle aspirates: suspended in tissue culture medium and store at 2-8°C (wet ice). Normal saline may be used if culture medium is unavailable. Transport time is kept to a minimum.
Special instructions: In all cases, notify the lab before the specimen is sent (508-793-6230). If possible, notify lab one day in advance. Specimens must be received by 5:00 pm on Friday, and by 3 pm the day before a holiday. If a late arrival is anticipated, please call the laboratory to confirm that the test can be performed. Send a complete requisition. Send all specimens at room temperature. Use adequate safety measures in transporting sample.
Director: Dr. Bruce Woda
Division of Anatomic Pathology
Manager: Ahmad Al-Attar, PhD.
UMass Memorial Medical Center
Three Biotech, One Innovation Drive
Worcester, MA 01605
Tel: (508)793-6230
